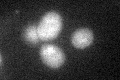

View description
Protein of unknown function; null mutation does not confer any obvious defects in growth, spore germination, viability, or carbohydrate utilization
Localization:
Intensity:
Fold change:
Significance:
-
C’ GFP library in SD

below threshold14.28 -
N' NOP1pr-GFP in SD

cytosol27.743 -
N' TEF2pr-mCherry in SD

below threshold5.52295 -
N' NATIVEpr-GFP in SD

below threshold17.2031 -
N' TEF2pr-VC and Cyto-VN in SD

#N/A0 -
C’ GFP library in SD+DTT
cytosol16.341.14No -
C’ GFP library in SD+H2O2

cytosol17.51.22No -
C’ GFP library in Starvation Media

cytosol17.591.23No -
C’ GFP library on the background of Pup2-DaMP

below threshold -
C’ GFP library on the background of CCT mutant

below threshold14.90931.04339No
